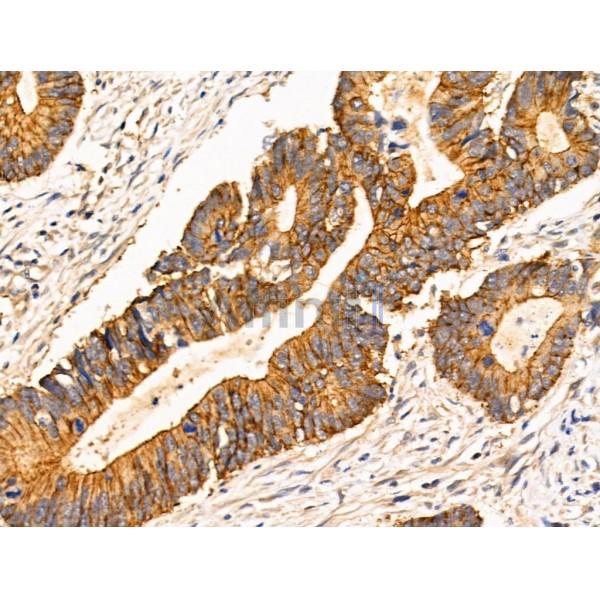
TRIM16 Antibody - AF0352 at 1/100 staining Human colorectal cancer by IHC-P.
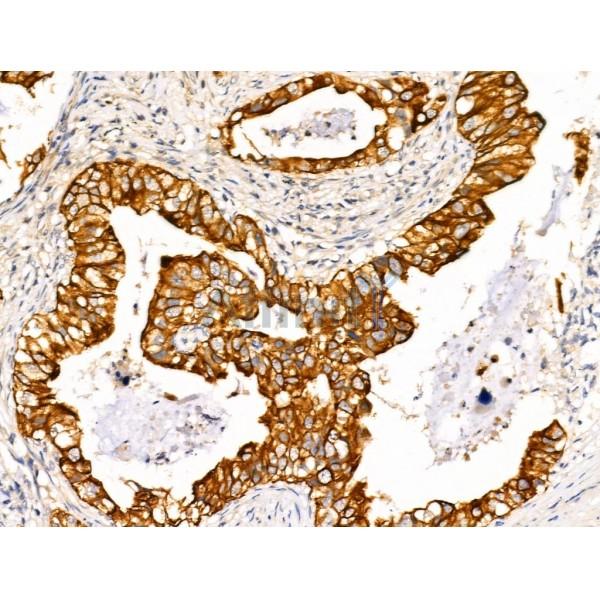
TRIM16 Antibody - AF0352 at 1/100 staining Human lung cancer by IHC-P.

TRIM16 Antibody - #AF0352
| Product: | TRIM16 Antibody |
| Catalog: | AF0352 |
| Description: | Rabbit polyclonal antibody to TRIM16 |
| Application: | WB IHC |
| Reactivity: | Human, Mouse, Rat |
| Mol.Wt.: | 63kDa(Observed); 64kD(Calculated). |
| Uniprot: | O95361 |
| RRID: | AB_2834197 |
Related Downloads
Protocols
Product Info
*The optimal dilutions should be determined by the end user. For optimal experimental results, antibody reuse is not recommended.
*Tips:
WB: For western blot detection of denatured protein samples. IHC: For immunohistochemical detection of paraffin sections (IHC-p) or frozen sections (IHC-f) of tissue samples. IF/ICC: For immunofluorescence detection of cell samples. ELISA(peptide): For ELISA detection of antigenic peptide.
Cite Format: Affinity Biosciences Cat# AF0352, RRID:AB_2834197.
Fold/Unfold
EBBP; Estrogen responsive B box protein; Estrogen-responsive B box protein; TRI16_HUMAN; TRIM 16; TRIM16; Tripartite motif containing 16; Tripartite motif containing protein 16; Tripartite motif-containing protein 16;
Immunogens
A synthesized peptide derived from human TRIM16, corresponding to a region within N-terminal amino acids.
Highest levels found in testis, ovary, small intestine, colon, placenta, heart, skeletal muscle and mammary gland. More highly expressed in the fetus than in the corresponding adult tissues. Expressed in basal keratinocytes.
- O95361 TRI16_HUMAN:
- Protein BLAST With
- NCBI/
- ExPASy/
- Uniprot
MAELDLMAPGPLPRATAQPPAPLSPDSGSPSPDSGSASPVEEEDVGSSEKLGRETEEQDSDSAEQGDPAGEGKEVLCDFCLDDTRRVKAVKSCLTCMVNYCEEHLQPHQVNIKLQSHLLTEPVKDHNWRYCPAHHSPLSAFCCPDQQCICQDCCQEHSGHTIVSLDAARRDKEAELQCTQLDLERKLKLNENAISRLQANQKSVLVSVSEVKAVAEMQFGELLAAVRKAQANVMLFLEEKEQAALSQANGIKAHLEYRSAEMEKSKQELERMAAISNTVQFLEEYCKFKNTEDITFPSVYVGLKDKLSGIRKVITESTVHLIQLLENYKKKLQEFSKEEEYDIRTQVSAVVQRKYWTSKPEPSTREQFLQYAYDITFDPDTAHKYLRLQEENRKVTNTTPWEHPYPDLPSRFLHWRQVLSQQSLYLHRYYFEVEIFGAGTYVGLTCKGIDRKGEERNSCISGNNFSWSLQWNGKEFTAWYSDMETPLKAGPFRRLGVYIDFPGGILSFYGVEYDTMTLVHKFACKFSEPVYAAFWLSKKENAIRIVDLGEEPEKPAPSLVGTAP
Research Backgrounds
E3 ubiquitin ligase that plays an essential role in the organization of autophagic response and ubiquitination upon lysosomal and phagosomal damages. Plays a role in the stress-induced biogenesis and degradation of protein aggresomes by regulating the p62-KEAP1-NRF2 signaling and particularly by modulating the ubiquitination levels and thus stability of NRF2. Acts as a scaffold protein and facilitates autophagic degradation of protein aggregates by interacting with p62/SQSTM, ATG16L1 and LC3B/MAP1LC3B. In turn, protects the cell against oxidative stress-induced cell death as a consequence of endomembrane damage.
Phosphorylated by ULK1.
Auto-ubiquitinates via its B-Boxes.
Cytoplasm.
Highest levels found in testis, ovary, small intestine, colon, placenta, heart, skeletal muscle and mammary gland. More highly expressed in the fetus than in the corresponding adult tissues. Expressed in basal keratinocytes.
Belongs to the TRIM/RBCC family.
References
Restrictive clause
Affinity Biosciences tests all products strictly. Citations are provided as a resource for additional applications that have not been validated by Affinity Biosciences. Please choose the appropriate format for each application and consult Materials and Methods sections for additional details about the use of any product in these publications.
For Research Use Only.
Not for use in diagnostic or therapeutic procedures. Not for resale. Not for distribution without written consent. Affinity Biosciences will not be held responsible for patent infringement or other violations that may occur with the use of our products. Affinity Biosciences, Affinity Biosciences Logo and all other trademarks are the property of Affinity Biosciences LTD.